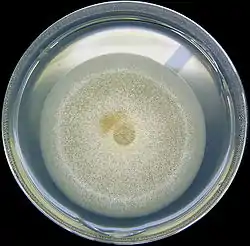

Aspergillus nidulans
Aspergillus nidulans (sin. Emericella nidulans) es una de las muchas especies de hongos filamentosos en el filo Ascomycota. Es un importante organismo de estudio en células eucariotas[1] y tiene una larga historia de su uso para estudios de una amplia gama de temas incluyendo problemas genéticos básicos (recombinación, reparar ADN, mutaciones), control de ciclo celular y patogénesis, y metabolismo de otras especies de Aspergillus[2] por más de 50 años.[3] Es la única especie en su género apta para formar esporas sexuales a través de la meiosis, pudiendo realizar cruzamientos de razas en laboratorio. A. nidulans es un hongo homotálico, capaz de autofertilizarse y formar cuerpo de fructificación en ausencia del compañero o pareja sexual.
| Aspergillus nidulans | ||
|---|---|---|
![]() | ||
| Taxonomía | ||
| Reino: | Fungi | |
| Filo: | Ascomycota | |
| Clase: | Eurotiomycetes | |
| Orden: | Eurotiales | |
| Familia: | Trichocomaceae | |
| Género: | Aspergillus | |
| Especie: |
A. nidulans G Winter 1884 | |
| Sinonimia | ||
Emericella nidulans | ||
Genoma
Su genoma secuenciado en el Instituto Broad, fue publicado en diciembre de 2005.[4] Tiene 30 millones de pares de bases en tamaño y está predicto que contiene alrededor de 9.500 genes sintetizadores de proteínas en ocho cromosomas.
Referencias
- Osmani SA, Mirabito PM (2004). «The early impact of genetics on our understanding of cell cycle regulation in Aspergillus nidulans». Fungal Genet Biol 41 (4): 401-10. PMID 14998523.
- Nierman WC, May G, Kim HS, Anderson MJ, Chen D, Denning DW (2005). «What the Aspergillus genomes have told us». Med Mycol. 43 Suppl 1: S3-5. PMID 16110785.
- Martinelli, S. D.; Kinghorn, J.R. (1994). Aspergillus: 50 years on. Elsevier. ISBN 0-444-81762-X.
- Galagan JE et al (2005). «Sequencing of Aspergillus nidulans and comparative analysis with A. fumigatus and A. oryzae.». Nature 438 (7071): 1105-15. PMID 16372000.
Enlaces externos
- Asperjilus nidulans genoma[https://www.webcitation.org/5YKqupmbt?url=http://www.broad.mit.edu/annotation/genome/aspergillus_nidulans/%5d
- Centro de Genética de Fungi Archivado el 1 de octubre de 2006 en Wayback Machine.